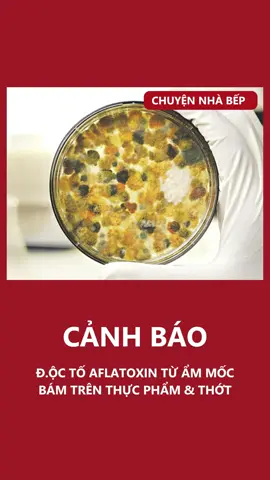

🖤|•lori sue•|🖤
Region: US
Thursday 28 August 2025 18:50:40 GMT
2111030
184355
365
6469
Music
Download
Comments
Skyla Lonethunder :
“Tonight is the night that i will fall for youu”
2025-09-26 16:01:55
57356
Naifs22 :
2025-09-28 13:28:33
13066
️ :
TONIGHT IS THE NIGHT THAT I’LL FALL FOR YOUUUU
2025-08-28 19:29:07
24242
M🫳🏻 :
It’s in her blood 🩸
2025-09-28 13:52:00
14129
Altaïr ibn La’Ahad :
did i hear tonight's the night?
2025-08-31 03:21:50
1082
علي :
2025-09-27 10:05:35
8152
pipluk :
tonight's the night
2025-08-30 17:24:44
2152
Daniella :
ITS NOT A PHASE, MOM!!!! 😂
2025-08-30 00:53:47
6507
A.F.L.S :
I don’t get it
2025-09-26 18:23:14
51
MxFabulous :
OVER AGAIN DON'T MAKE ME CHANGE MY MIND!!!
2025-09-27 06:48:58
889
️fn :
2025-09-27 07:13:34
1622
Nasi Bujang 🍚 :
OVER AGAINNNNNNNN!!!!
2025-09-28 08:42:46
811
Bambi 🏴 :
I can't tell if your face is one of fear or excitement 😂
2025-08-30 11:51:32
864
Addie Ventress :
lol she even made the correct voice
2025-09-27 05:08:51
3457
christhecollector0 :
So it begins.....the next metal head in the family finally.
2025-08-30 04:46:19
3592
n. :
its ellie goulding - still falling for you🤣
2025-08-30 23:00:28
5
TriggerStingray :
"Tonight is the night THAT WE RUN"
2025-09-28 16:18:43
558
StrayKat :
So where did she hear it 😂
2025-08-31 14:00:13
16
Nina B :
alguien sabe que canción es?
2025-09-27 00:33:25
0
Doug :
"what was you singing"
2025-10-01 22:59:32
1
Potato :
she in a toy car :
2025-08-31 08:19:23
73
Reecetowers :
Because tonight will be the night I fall for u over again don’t make me change my mind
2025-09-03 08:53:53
3272
Arktisk Cruiser :
but she has definitely heard the exaggerated version 😂 Becoose tounåight will be the nåight dat I will fall får yu
2025-08-30 13:46:43
1151
katty_vasileiou :
OVER AGAIN.... DON'T MAKE ME CHANGE MY MIND
2025-08-30 13:31:58
140
setzuxlyxgv :
2025-09-27 07:43:18
68
To see more videos from user @lorisue23, please go to the Tikwm
homepage.